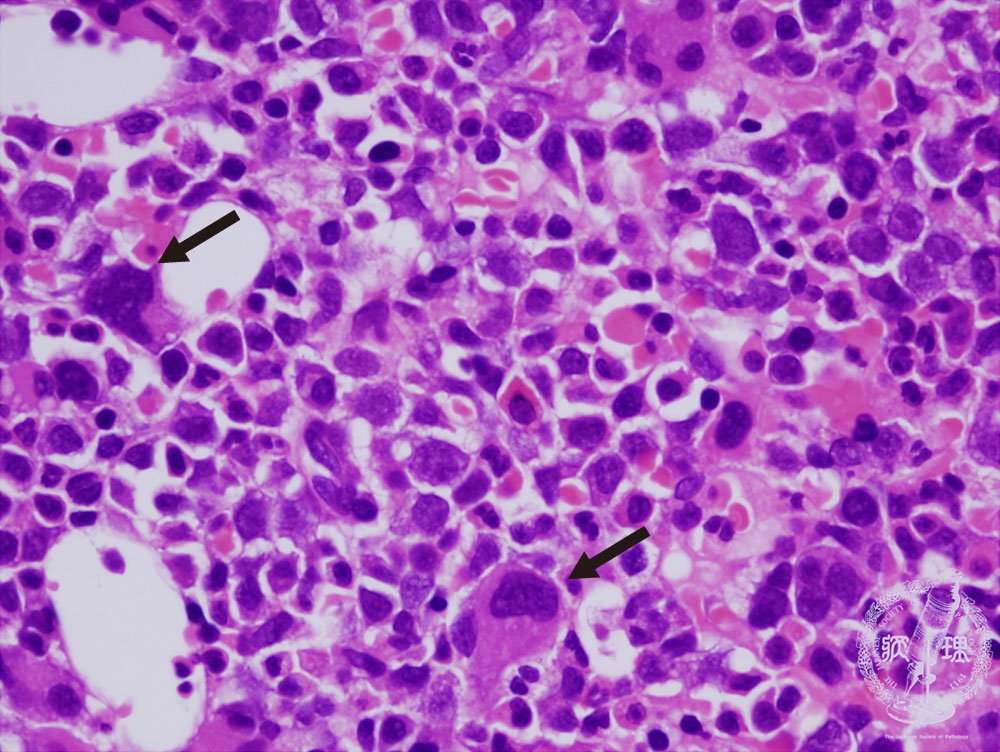
MDSを抱えて暮らしている人は何人いますか?

骨髄異形成症候群 (MDS) は、新しい血球の産生に問題を引き起こす一連の状態です。 MDS では、骨髄内の血球に異常が生じ、健康な赤血球、白血球、血小板が減少します。
赤血球が少なすぎると、息切れや疲労感などの貧血の症状が引き起こされます。白血球が不足すると、感染症がより頻繁に起こる可能性もあります。血小板が少なすぎると、あざや出血のリスクが高まります。
MDS には 6 つのタイプがあります。種類は、どの血球が影響を受けているか、およびそれらの細胞が顕微鏡でどのように異常に見えるかに基づいています。
MDSを抱えて暮らしている人は何人いますか?
MDS は最も一般的な血液がんの 1 つです。米国では 60,000 人から 170,000 人がこの症状を抱えて暮らしています。米国では毎年最大 20,000 人が MDS と診断されています。

MDS を取得するのは誰ですか?
専門家は、MDS の原因を正確に知りません。この状態は女性および次のような人々によく見られます。
- 50歳以上です
- がん治療のために化学療法を受けている
- 喫煙歴がある
- MDSの家族歴がある、またはファンコニ貧血やダイアモンドブラックファン貧血などの遺伝性疾患がある
- ベンゼンなどの化学物質にさらされたことがある

診断を受けるまでにどのくらい時間がかかりますか?
MDS は数か月から数年かけてゆっくりと進行するため、診断には時間がかかることがあります。白血病と間違われやすいのも特徴です。
多くの場合、MDS は初期段階では症状を引き起こしません。医師は、血液検査中に別の理由で血球数の低下を発見することがあります。骨髄穿刺と骨髄生検によって診断が確定します。

MDS は常に AML に変わりますか?
MDS 患者の約 3 人に 1 人が、血液がんの一種である急性骨髄性白血病 (AML) を発症します。 AML に進行する可能性は、所有するデータシートの種類によって異なります。
医師は、骨髄内の異常な血球の数やその他の要因に基づいて、MDS を低リスク型と高リスク型に分類します。 MDS患者の約4人に1人が高リスクタイプです。高リスク MDS は、低リスク MDS よりも AML に移行する可能性が高くなります。

診断とケアにはどのような格差が存在しますか?
MDS の診断とケアには、人種、民族、性別の違いが存在します。
2022年の研究では、ヒスパニック系や黒人に比べて非ヒスパニック系の白人がMDSにかかる可能性が最も高いことが判明した。しかし、50歳未満ではMDSの割合は黒人の方が高かった。黒人の生存率も、ヒスパニック系および非ヒスパニック系の白人よりも高かった。
2021年の研究によると、女性は男性よりわずかに若い年齢でMDSと診断されます。女性と男性は、通常、異なる遺伝子変異を持っています。また、MDS のリスクが低い女性は男性よりも生存率が高いですが、MDS のリスクが高い女性はそうではありません。

MDSケアチームには誰がいる可能性がありますか?
MDS ケア チームには、次のようないくつかの異なる種類の専門家が含まれます。
- 腫瘍学者
- 血液学者
- 骨髄移植の専門医
- 医師助手 (PA)
- 看護師
- 看護師
- ソーシャルワーカー
- 栄養士

どのような種類の治療法がありますか?
MDSの治療法には主に3種類あります。
支持療法
これらの治療法は、血球数の低下によって引き起こされる症状を軽減し、気分を良くします。支持療法には、血球数を増やすための輸血と成長因子、感染症の予防または治療のための抗生物質が含まれます。
薬物療法
いくつかの薬は MDS の進行を遅らせます。これらには次のものが含まれます。
- レナリドマイド (Revlimid)、特定の MDS サブタイプ (5q 欠失細胞遺伝学的異常) 用
- 抗胸腺細胞グロブリン(ATG)などの免疫抑制薬
- アザシチジン (Vidaza) とデシタビン (Dacogen) は、骨髄による新しい健康な血球の生成を助けます。
- MDS成人向けのデシタビンとセダズリジンを組み合わせた錠剤Inqovi
幹細胞移植による化学療法
化学療法は骨髄内の異常な血球を殺します。化学療法の後、幹細胞を自分の血液や骨髄、あるいはドナーの骨髄から採取して置き換えます。

持ち帰り
MDS は、新しく健康な赤血球、白血球、血小板を生成する体の能力に影響を与えます。どのくらいの速さで進行し、AML になるかどうかは、お持ちのデータシートの種類によって異なります。リスクの高い MDS は、リスクの低い MDS よりも AML に移行する可能性が高くなります。
血球数が低下すると、疲労、息切れ、出血やあざ、感染症などの症状が発生することがあります。
輸血などの支持療法は、これらの症状を軽減するのに役立ちます。薬物療法と幹細胞移植は、体がより健康な血球を生成するのを助け、MDS を遅らせます。
参考文献
- https://www.aamds.org/diseases/acute-myeloid-leukemia-aml
- https://www.lls.org/research/myelodyslastic-syndrome-mds-research-funded-lls
- https://ashpublications.org/blood/article/138/Supplement%201/1984/480957/Gender-Disparities-in-Myelodysplast-Syndromes
- https://www.tandfonline.com/doi/abs/10.1080/10428194.2022.2032034?journalCode=ilal20
骨髄異形成症候群(MDS)について知っておくべき重要な事実・関連動画
免責事項: 健康百科事典ブログは、すべての情報が事実に基づき、包括的で最新のものであるよう努めています。しかし、この記事は、資格を持つ医療専門家の知識や専門性の代替として使用されるべきではありません。薬を服用する前には、必ず医師または他の医療専門家に相談してください。ここに記載されている情報は変更される可能性があり、すべての可能な用途、指示、注意事項、警告、薬物相互作用、アレルギー反応、副作用を網羅することを意図しているわけではありません。特定の薬物または薬物の組み合わせに関する警告や情報が記載されていない場合でも、その薬物や組み合わせがすべての患者やすべての用途において安全、有効、適切であることを意味するものではありません。
